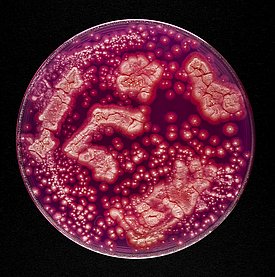

Leben bei frostigen Temperaturen – Biobank von Mikroorganismen aus extremen Lebensräumen
2023 - 2028
FinanzierungDie kalten Lebensräume unserer Schweizer Alpen und der Arktis befinden sich in einem Wandel und drohen zukünftig ganz oder teilweise zu verschwinden. Mit ihnen verschwinden auch eine noch kaum erforschte Vielfalt an Mikroorganismen, die sich ans Leben an vermeintlich lebensfeindlichen Orten angepasst haben. Durch die Kryokonservation von ca. 1'500 Mikroorganismen ebendieser Lebensräume kann ein Teil der heutigen Biodiversität in Biobanken erhalten bleiben.
Inhalt ¶
- Was sind Mikroorganismen?
- Warum werden Mikroorganismen aus kalten Lebensräumen erforscht?
- Aus welchen Lebensräumen wurden Mikroorganismen isoliert?
- Was ist Permafrost?
- Welchen Lebensbedingungen sind Mikroorganismen in den untersuchten Lebensräumen ausgesetzt?
- Welche Mikroorganismen aus den untersuchten Lebensräumen wachsen auch unter Laborbedingungen?
- Isolierte Bakterien
- Isolierte Pilze
- Häufig gestellte Fragen
Was sind Mikroorganismen? ¶
Mikroorganismen sind Lebewesen, die mit blossem Auge nicht sichtbar sind. Dazu zählen die Bakterien, Archaeen, Mikropilze und Mikroalgen, und auch Viren, die genaugenommen keine Lebewesen sind. Schätzungen zufolge gibt es mehrere Millionen bis zu einer Trillion verschiedene mikrobielle Taxa, davon sind wahrscheinlich ein Grossteil Bakterien. Von der geschätzten Diversität an mikrobiellen Taxa sind bis jetzt nur ein winzig kleiner Bruchteil bekannt (~10'000 Bakterien; ~400 Archaeen; ~150'000 Pilze, obwohl nicht alle Pilze Mikroorganismen sind; ~35'000 mikroskopische Algen; ~11'000 Viren), und ein noch kleinerer Bruchteil davon ist im Labor kultivierbar.
Viele terrestrische, marine oder mit Menschen in Verbindung stehende prokaryotische Taxa (Bakterien und Archaeen) kommen auf allen Kontinenten oder in beiden Hemisphären vor. Schaut man aber Lebensräume mit extremeren Lebensbedingungen an, findet man Taxa, die weniger weit verbreitet sind und nur an gewissen Orten vorkommen.
Warum werden Mikroorganismen aus kalten Lebensräumen erforscht? ¶
Bis zum Ende des Jahrhunderts werden die Temperaturen in alpinen Regionen weiter ansteigen, die Schneedecke kleiner, der Permafrost auftauen, die Auftauschicht in weitere Bodentiefen vordringen und Gletscher werden grösstenteils verschwinden.
In arktischen Regionen werden schon jetzt höhere Temperaturen als je zuvor gemessen und die Meereisfläche im Winter ist auf einem rekordtiefen Niveau. Die Schneedecke und das Meereis werden zukünftig schmaler und Gletscher weiter schmelzen. Bis zum Ende des Jahrhunderts wird Permafrost wärmer und wird bis in tiefere Bodenschichten auftauen.
Die kalten Lebensräume in alpinen Regionen wie den Schweizer Alpen und in arktischen Regionen werden sich zukünftig stark verändern oder gar ganz verschwinden. Mit ihnen eine Vielfalt an Mikroorganismen, die bisher noch kaum erforscht wurden. Durch die Kryokonservation von Mikroorganismen aus kalten Lebensräumen der Schweizer Alpen und der Arktis kann ein Teil der unbekannten Biodiversität in Biobanken erhalten werden.
Die Kryokonservierung von Mikroorganismen aus kalten Lebensräumen ist nicht nur zur besseren Beschreibung des Lebensraums oder zur Bestimmung neuer Spezies bestimmt. Gewisse Eigenschaften, die es Mikroorganismen ermöglichen, auch bei kalten Temperaturen zu überleben könnten auch für biotechnologische, industrielle und medizinische Anwendungen oder zur Bioremediation interessant sein. So kann man Isolate auf die Produktion von sekundären Metaboliten, kälteaktiven Enzymen oder sonstige nützliche Eigenschaften untersuchen.
Antibiotika sind aus der Medizin nicht mehr wegzudenken und Pestizide sind essentiell für die Landwirtschaft. Da Mikroorganismen aus kalten Lebensräumen noch wenig erforscht sind, könnten sie eine wahre Schatztruhe an bisher unbekannten Biomolekülen mit antibiotischer, pestizider, antitumor, immunsuppressiver, antioxidantischer oder pflanzenwachstumsfördernder Eigenschaften sein.
Zudem könnten kälteaktive Enzyme dort eingesetzt werden, wo enzymatische Reaktionen bisher nur bei erhöhten Temperaturen effizient waren. Mikrobielle Polysaccharide oder ganze Mikroorganismen können zur Bioremediation (zum Beispiel Sanierung von mit Schwermetall, Öl oder Pestiziden belasteten Böden und Gewässer) oder zur Abwasserreinigung benutzt werden. Mikrobielle Tenside zur Reinigung bei tiefen Temperaturen oder um die flüssigen Eigenschaften von Flüssigkeiten bei kalten Temperaturen zu erhalten. Anti-frost Proteine können auf bestimmten Materialien oder in Lebensmitteln eingesetzt werden, um die Frostbildung zu reduzieren. Mikrobielle Polyester könnten eine Alternative zu konventionellem Plastik sein. Die Produktion von mehrfach ungesättigten Fettsäuren kann in der Lebensmittelindustrie oder der Medizin Verwendung finden. Pigmente wie Carotinoide könnten als biologischer Ersatz bisheriger Färbemittel eingesetzt werden, aber auch als Antioxidantien.
Aus welchen Lebensräumen wurden Mikroorganismen isoliert? ¶
Hochalpine Böden und Gletscher
Muot da Barba Peider (Schafberg): Boden (Oberschicht und Permafrost) der Bergspitze des Muot da Barba Peider im Oberengadin bei 2979 m. ü. M.. Der Nordhang ist nur spärlich bewachsen und ab 2 m Tiefe kommt Permafrost vor.
Val Lavirun: Boden (Oberschicht und Permafrost) vom Val Lavirun im Oberengadin. Die Erde dort ist kaum bewachsen, sauer und ist durch hohe Konzentrationen von Aluminium, Arsen und Eisen ausgezeichnet. Ab 1 m Tiefe kommt Permafrost vor.
Dammagletscher: Gesteinsmaterial vom Gletschervorfeld und der Gletscherzunge des Dammagletschers bei etwa 2100 m. ü. M. in der Zentralschweiz. Das Gletschervorfeld ist frei von Pflanzen und besteht aus steinigem Untergrund. Die Gletscherzunge ist mit feinem Gestein bedeckt.
Arktische Böden
Station Nord: Boden (Oberschicht) von der Villum Forschungsstation in Nordgrönland. Der Boden ist sporadisch mit Saxifraga bewachsen und ab 40 cm Tiefe kommt Permafrost vor.
Svalbard: Plastikabfall gesammelt an einem Ufer des Billefjorden und Tempelfjorden des Svalbard Archipel. An den Ufern hatte es viel Gestein, kleinere Pflanzen, Schwemmholz und viel Plastikabfall.
Russland: Erde von der Pioneer Island, Vize Island, Uedineniya Island und vom Cape Baranov. Auf der Pioneer Island gibt es steinigen, braunen und lehmigen Boden, auf der Vize Island Klippen mit schlammigem und lehmigem Boden und auf der Uedineniya Island sandiges Flachland, das entweder kaum oder dicht mit Gras bewachsen ist.
Was ist Permafrost? ¶
Permafrost ist Untergrund (Boden, Gestein, Sand, Sediment), der für mindestens zwei Jahre in Folge eine Temperatur von unter 0° C hat. Permafrost gibt es in den Polarregionen und im Hochgebirge (zum Beispiel in unseren Schweizer Alpen). Er bedeckt etwa 20 % der Fläche der nördlichen Hemisphäre. In der Schweiz kommt Permafrost grösstenteils bei über 2600 m ü. M. vor und bedeckt schätzungsweise eine Fläche von 3 – 5 % des Landes. Er ist überdeckt mit einer Auftauschicht (active layer), die im Sommer auftaut und im Winter wieder einfriert.
Welchen Lebensbedingungen sind Mikroorganismen in den untersuchten Lebensräumen ausgesetzt? ¶
Hochalpine Böden sind häufig mit Schnee bedeckt und sind grösseren Fluktuationen von Temperatur und Feuchtigkeit ausgesetzt. Die Temperatur fällt häufig unter den Gefrierpunkt. Zudem ist der Rohboden mit seiner spärlichen Vegetation starker UV-Strahlung ausgesetzt. Durch die ungünstigen Umweltbedingungen und Erosion sind diese Böden normalerweise flachgründig, steinig, ohne eine Humusschicht und wenig fruchtbar. Nährstoffe und organisches Material sind häufig sehr limitiert und kommen hauptsächlich in den oberen Schichten vor, weniger im hochalpinen Permafrost. Im Vergleich zu arktischen Böden, haben hochalpine Böden eine relativ dicke Auftauschicht und einen wärmeren Permafrost (1 – 3 Grade unter dem Gefrierpunkt). Arktische Böden hingegen enthalten mehr Nährstoffe, organisches Material und Wasser als hochalpine Böden.
Die Böden im Gletschervorfeld nach dem Gletscherrückzug haben ebenfalls einen tiefen Gehalt an organischem Material und Nährstoffen. Diese Böden haben keinen oder nur spärlichen Pflanzenbewuchs und sind starker UV-Strahlung ausgesetzt. Zudem gibt es grössere Fluktuationen von Temperatur und Feuchtigkeit mit regelmässigen Gefrier-Tauzyklen.
Welche Mikroorganismen aus den untersuchten Lebensräumen wachsen auch unter Laborbedingungen? ¶
Die gesamte Sammlung wird dominiert durch Bakterien der Phyla Actinobacteria (neu Actinomycetota) und Proteobacteria (neu Pseudomonadota), weitere bakterielle Isolate gehören zum Phylum Bacteroidetes (neu Bacteroidota).
Pilze wurden viel weniger häufig isoliert als Bakterien. Die Pilzisolate in der Sammlung gehören alle zu den Phyla Ascomycota, Basidiomycota oder Mucoromycota.
Im Folgenden werden die am häufigsten isolierten Genera der oben erwähnten Phyla etwas genauer vorgestellt.
Die Nomenklatur von Mikroorganismen wird ständig ergänzt und angepasst. Zum besseren Verständnis werden hier die alten, bekannten Phyla für Bakterien verwendet und in Klammern ergänzt mit den neuen, vereinheitlichten Namen.

Isolierte Bakterien ¶
Actinobacteria (neu Actinomycetota):
Arthrobacter (252 Isolate)
Arthrobacter sind weit verbreitet und kommen in terrestrischen und aquatischen Lebensräumen oder assoziiert mit Pflanzen und Tieren vor. Viele von ihnen sind mesophil, einige aber auch psychrotolerant oder psychrophil. Die meisten Spezies wachsen abhängig von ihrer Wachstumsphase entweder als gram-negative Stäbchen in der exponentiellen Phase oder als gram-positive Kokken in der stationären Phase. Arthrobacter sind metabolisch vielfältig und können schwer abbaubare synthetische Stoffe und toxische Substanzen abbauen. Einige können auch Hitze, Kälte, Nährstoffmangel oder Schwermetalle tolerieren.
Pseudarthrobacter (62 Isolate)
Das Genus Pseudarthrobacter ist ein relativ neues Genus (2016) und beherbergt ehemalige Arthrobacter Spezies, die aufgrund ihrer einzigartigen Zellwandbestandteilen reklassifiziert wurden. Wie auch Spezies des Genus Arthrobacter, wachsen Pseudarthrobacter abhängig von der Wachstumsphase entweder in Stäbchen- oder Kokkenform. Pseudarthrobacter sind sehr häufig in Böden vorzufinden.
Streptomyces (56 Isolate)
Streptomyces haben einen komplexen Lebenszyklus: sie wachsen als vegetative Hyphen und bilden ein Myzel; bei Nährstoffmangel können sie Sporen bilden, um lange Zeiten zu überdauern und bei guten Bedingungen können diese Sporen wieder keimen und ein neues Myzel bilden. Sie leben hauptsächlich in Böden.
Streptomyces spielen eine wichtige Rolle im Recycling von organischem Material. So können sie komplexes und schwer abzubauendes pflanzliches und tierisches Material degradieren, einige aber auch Gummi, Kohlenwasserstoffe oder Plastik.
Am besten bekannt jedoch ist das Genus Streptomyces für die Produktion von einer Vielfalt an bioaktiven sekundären Metaboliten mit antibiotischer, antiviraler, zytotoxischer, antitumor, immunosuppressiver, antioxidantischer, insektizider, herbizider oder pflanzenwachstumsfördernder Wirkung. Allein 70 – 80 % der bioaktiven sekundären Metaboliten mit pharmazeutischer oder agrochemischer Verwendung werden von Streptomyces produziert.
Rhodococcus (39 Isolate)
Rhodococcus kommen in terrestrischen und aquatischen Lebensräumen und auf Pflanzen und Tieren vor. Auch überleben sie harsche Umweltbedingungen wie Kälte, hohe pH-Werte, Trockenheit, hohe Kohlenwasserstoff Konzentrationen und hohe Konzentrationen an Lösungsmitteln. Sie sind metabolisch versatil und können toxische und schwer zu zersetzende Substanzen (unter anderem Plastik) abbauen. Rhodococcus haben eine hydrophobe Zelloberfläche und können Tenside produzieren, was hilfreich ist, hydrophobe Substanzen abzubauen.
Leifsonia (31 Isolate)
Leifsonia kommen in terrestrischen und aquatischen Lebensräumen und assoziiert mit Pflanzen und Tieren vor. Eine Spezies ist als Pflanzenpathogen bekannt. Leifsonia können Cellulose produzieren, die industriell verwendet werden könnte.
Frigoribacterium (8 Isolate)
Frigoribacterium sind mesophile oder psychrophile Bakterien, die aus Staub, der Luft, granitischem Sediment des Dammagletschers, Wurzeln von Halophyten oder salziger Erde isoliert wurden. Bisher wurden erst drei Spezies beschrieben.
Proteobacteria (neu Pseudomonadota)
Pseudomonas (99 Isolate)
Pseudomonas sind mesophil, einige auch psychrophil. Sie sind sehr weit verbreitet, wurden aber häufig aus terrestrischen und aquatischen Lebensräumen oder von Pflanzen isoliert, seltener von Tieren. Einige Spezies können Enzyme sekretieren, um extrazelluläres organisches Material abzubauen. Zudem können einige komplexe und toxische Substanzen abbauen und eine Toleranz für Lösungsmittel entwickeln. Einige Pseudomonas können ausserdem Resistenzen für Schwermetalle besitzen. Gewisse Pseudomonas Spezies produzieren auch Antimykotika, die wichtig für den Pflanzenschutz sind.
Massilia (42 Isolate)
Massilia kommen in terrestrischen, aber auch aquatischen Lebensräumen vor. Einige sind psychrophil. Einige Spezies produzieren das Pigment Violacein, das antibiotische und zytotoxische Wirkungen hat.
Burkholderia (27 Isolate)
Burkholderia sind mesophil und in sehr vielen verschiedenen Nischen vorzufinden, hauptsächlich aber in terrestrischen Lebensräumen und in enger Beziehung mit Pflanzen, Tieren und Pilzen, wo sie sowohl positive als auch negative Effekte auf ihren Wirt haben. Das Genus Burkholderia ist möglicherweise generell säuretolerant. Verschiedene Spezies können unter anderem schwer abbaubare organische Stoffe degradieren oder Stickstoff fixieren. Einige Spezies überleben auch in extrem nährstoffarmen Lebensräumen und gelten als universelle Kontaminanten. Burkholderia produzieren Antibiotika, Herbizide und Insektizide.
Sphingomonas (25 Isolate)
Sphingomonas sind weit verbreitet, kommen aber hauptsächlich in terrestrischen und aquatischen Lebensräumen vor. Sie können komplexe und toxische Substanzen abbauen. Einige Sphingomonas besitzen auch Resistenzen für Schwermetalle. In Assoziation mit Pflanzen können sie die abiotische Stresstoleranz erhöhen und wachstumsfördernde Effekte haben.
Collimonas (25 Isolate)
Collimonas kommen in terrestrischen Lebensräumen vor, die leicht sauer und nährstoffarm sind und wo Pilze anwesend sind. Sie können Pilze parasitieren und dabei ihr Wachstum einschränken. Zudem können sie Mineralien und Gestein mineralisieren. Einige Collimonas produzieren auch das antibiotische und zytotoxische Pigment Violacein.
Janthinobacterium (25 Isolate)
Einige Janthinobacterium produzieren das violette Pigment Violacein und einige psychrotrophe Janthinobacterium Isolate produzieren das rote Pigment Prodigiosin. Beide Pigmente haben antibiotische und zytotoxische Wirkungen.
Variovorax (22 Isolate)
Variovorax kommen in terrestrischen und aquatischen Lebensräumen vor und in chemisch kontaminierten Böden. Sie können eine Vielfalt an organischen Stoffen als Kohlenstoffquelle verwenden (daher der Name Variovorax) und sehr komplexe und toxische Substanzen abbauen. Einige Isolate können autotroph wachsen (Wachstum durch Verwendung von CO2 als Kohlenstoffquelle und anorganische chemische Stoffe als Energiequelle). Variovorax zeigen auch Anzeichen dafür, dass sie das Pflanzenwachstum fördern können.
Noviherbaspirillum (9 Isolate)
Noviherbaspirillum ist ein neueres Genus (2013), das einige reklassifizierte Herbaspirillum Spezies und neuere, aus der Umwelt isolierte Spezies beherbergt.
Bacteroidetes (neu Bacteroidota)
Hymenobacter (24 Isolate)
Einige Hymenobacter Spezies sind resistent gegen Kälte, UV- und Gammastrahlung.
Mucilaginibacter (23 Isolate)
Mucilaginibacter kommen in diversen terrestrischen und aquatischen Lebensräumen vor. In Assoziation mit Pflanzen haben sie wachstumsfördernde Eigenschaften. Zudem können sie organisches Material abbauen.
Flavobacterium (21 Isolate)
Flavobacterium kommen in terrestrischen und aquatischen Lebensräumen bei temperaten und kalten Temperaturen vor. Einige Spezies sind salz- und gefriertolerant und einige Spezies sind als Fischpathogene bekannt. Sie können einige komplexe organische Substanzen abbauen. Ausserdem sind sie eine mögliche Quelle für biotechnologisch interessante kälteaktive Enzyme.
Pedobacter (10 Isolate)
Pedobacter kommen in terrestrischen und aquatischen Lebensräumen bei temperaten und kalten Temperaturen vor. Einige Spezies produzieren Heparinasen und Chondroitinasen, welche potenzielle medizinische Anwendungen haben (Herstellung von gerinnungshemmenden Medikamenten bzw. Förderung der Heilung nach Rückenmarksverletzungen).
Ohtaekwangia (7 Isolate)
Ohtaekwangia wurden erstmals aus Sand isoliert und bisher wurden erst zwei Spezies beschrieben. Gemäss metagenomischen Analysen kommen Ohtaekwangia auch in Erde assoziiert mit Mais- und Gurkenwurzeln vor.
Isolierte Pilze ¶
Ascomycota
Pseudogymnoascus (70 Isolate)
Einige Pseudogymnoascus Spezies sind als Pathogene bekannt und verursachen das «White-Nose Syndrom» in Fledermäusen. Einige andere Pseudogymnoascus produzieren antibakterielle, antimykotische und zytotoxische sekundäre Metaboliten.
Penicillium (13 Isolate)
Das Genus Penicillium ist wohl am besten bekannt für die Entdeckung von Penicillin. Neben Penicillin produzieren Penicillium eine Vielfalt an anderen antimikrobiellen, antiviralen, antimykotischen, antioxidantischen, antitumor, immunosuppressiven und cholesterinsenkenden sekundären Metaboliten. Zudem produzieren sie Enzyme, die organisches Material abbauen und sie können mit Schwermetallen und toxischen Substanzen verunreinigte Böden sanieren. Penicillium haben auch pflanzenwachstumsfördernde Eigenschaften.
Lachnellula (5 Isolate)
Eine Lachnellula Spezies verursacht Lärchenkrebs. Andere Spezies produzieren die antimykotische Substanz Lachnellulon. Ausserdem wurde ein Lachnellula Isolat gefunden, das Bioplastik degradieren kann.
Basidiomycota
Phenoliferia (Hefepilz; 29 Isolate)
Phenoliferia sind psychrophil und sind in der Antarktis und Arktis weit verbreitet. Sie können Pektin abbauen.
Mrakia (Hefepilz; 11 Isolate)
Mrakia sind psychrophil und weit verbreitet in der Antarktis, kommen aber auch in anderen kalten Regionen vor. Sie können verschiedene organische Materialen abbauen und zeigen extrazelluläre enzymatische Aktivitäten. Durch Fermentation können sie Ethanol produzieren.
Dioszegia (Hefepilz; 7 Isolate)
Dioszegia kommen in kalten Lebensräumen und auf Pflanzen vor. Sie produzieren Carotinoide und Mycosporine (beides antioxidative Pigmente) und sind UV-tolerant. Sie zeigen auch extrazelluläre enzymatische Aktivitäten.
Leucosporidium (Hefepilz; 7 Isolate)
Leucosporidium produzieren anti-Frost Proteine. Zudem produzieren sie Enzyme mit antitumoraler Aktivität.
Naganishia (früher Cryptococcus) (Hefepilz; 7 Isolate)
Zwei Naganishia Spezies sind opportunistische humane Pathogene. Naganishia aus der Antarktis zeigen antibiotische und extrazelluläre enzymatische Aktivitäten.
Solicoccozyma (Hefepilz; 6 Isolate)
Solicoccozyma kommen häufig in terrestrischen Lebensräumen vor. Sie können potenziell pflanzenwachstumsfördernd sein und könnten für die Herstellung von Biokraftstoff interessant sein.
Cystobasidium (Hefepilz; 5 Isolate)
Cystobasidium zeigen extrazelluläre enzymatische Aktivitäten. Zudem produzieren sie Carotinoide, die biotechnologisch interessant sein könnten. Ein Cystobasidium Isolat war fähig, Bioelektrizität und Biowasserstoff herzustellen.
Mucoromycota
Mortierella (22 Isolate)
Mortierella kommen häufig in terrestrischen Lebensräumen vor, oft auch in kalten Lebensräumen. Sie werden in der Lebensmittelindustrie zur Produktion von mehrfach ungesättigten Fettsäuren verwendet. Sie haben auch pflanzenwachstumsfördernde Eigenschaften. Zudem können Mortierella Granit auflösen.
Mucor (4 Isolate)
Mucor kommen in feuchten Lebensräumen vor und gehören zu den ersten, die neue Lebensräume besiedeln. Einige sind bekannt als Humanpathogene. Zudem gilt eine Spezies als Modellorganismus in der Pilzgenetik. Ausserdem produzieren Mucor Carotinoide und Enzyme, die organisches Material abbauen, Granit auflösen und interessant für eine mögliche industrielle Biodiesel Produktion sind. Auch werden sie zur Fermentation von Lebensmitteln (z.B. Käse oder Tempeh) verwendet.
- Beispiele komplexe und toxische Substanzen: polyzyklische/halogenierte/aromatische/phenolische/nitroaromatische Kohlenwasserstoffe und Derivate davon (z.B. Herbizide, Pestizide, Insektizide, Trichlorethylen, Chlorophenol, Biphenyl, Naphthalin)
- Beispiele komplexes pflanzliches und tierisches Material/organisches Material: Polysaccharide (Cellulose, Chitin, Stärke, Pektin, Xylan), Proteine, Lignocellulose, Lignin
- Beispiele Schwermetalle: Kupfer, Silber, Aluminium, Quecksilber, Kobalt, Zink, Kadmium
Häufig gestellte Fragen ¶
Wurden durch die Isolation von Mikroorganismen aus den untersuchten Lebensräumen auch neue Spezies identifiziert?
Ja. Zum einen wurde das neue Hefegenus Cryolevonia auf dem Muot da Barba Peider entdeckt, zum anderen wurde eine neue Spezies von Glaciimonas vom Dammagletscher isoliert.
Zwar keine neue Spezies, aber es wurde ein Bakterium (Granulicella) des Phylum Acidobacteria isoliert. Metagenomische Analysen zeigen, dass dieses Phylum Im Boden sehr häufig vorkommt und in der Umwelt sehr weit verbreitet ist, jedoch sind sie nur schwer im Labor kultivierbar und dementsprechend in Sammlungen unterrepräsentiert.
Ausserdem gibt es viele Isolate, deren 16S oder ITS rRNA Sequenz eine relativ tiefe Übereinstimmung (< 97 %) mit bisher sequenzierten Isolaten in Datenbanken haben und potenzielle neue Spezies sein könnten. Unter anderem sind dies alle Isolate von Ohtaekwangia, und mehrere Isolate von Collimonas, Hymenobacter, Rhodococcus, Pseudarthrobacter, Streptomyces, Lachnellula und Mortierella.
Links ¶
Publizierter Datensatz: https://www.doi.org/10.16904/envidat.490
Tages-Anzeiger Magazin, 14.05.2026: Blatten: Wie der Klimawandel Bergdörfer bedroht
Orf, 07.07.2025: Gletscherbakterien: Forschung als Wettlauf mit der Zeit - science.ORF.at
SWI swissinfo.ch, 05.01.2025: Secrets revealed by melting Swiss glaciers could eat plastic and cure disease
SWI swissinfo.ch, 10.12.2024: Unveiling Ancient Life: Microorganisms in Melting Glaciers in Swiss Alps
WSL-Magazin Diagonal, 2024/2: Klein, aber oho: Wir schauen ganz genau hin
Radio SRF 2 Kultur, Wissenschaftsmagazin, 13.06.2020: Forscher finden neue Bakterienarten im Permafrost
Das unsichtbare Aussterben von Mikroorganismen unterstreicht die dringende Notwendigkeit, die mikrobielle Vielfalt zu erhalten, was Initiativen wie die SwissBioCollections veranlasst, diese Vielfalt zu erfassen und zu sichern.
Die Microbiota Vault-Initiative errichtet in der Schweiz eine Backup-Biobank und Datenbank zur langfristigen Erhaltung der mikrobiellen Biodiversität, die für die Gesundheit von Mensch und Planet von entscheidender Bedeutung ist.
Website für Buch 'unearthed' ausserhalb der Schweiz: https://www.ideabooks.nl/9782839936194-rahel-oberhummer-unearthed
Persönlicher Kontakt für Buch 'unearthed' innerhalb der Schweiz: contact(at)raheloberhummer.ch
Weitere Projekte ¶
Referenzen ¶
1. Home | PERMOS – Swiss Permafrost Monitorinig Network, Accessed: 01.03.2024
2. Permafrost | Schnee, Gletscher und Permafrost erklärt (naturwissenschaften.ch), Accessed: 01.03.2024
3. Global Terrestrial Network for Permafrost (GTN-P) - Home (arcticportal.org), Accessed: 01.03.2024
4. Special Report on the Ocean and Cryosphere in a Changing Climate — (ipcc.ch), Accessed: 01.03.2024
5. Whitman, W. B. (Ed.). (2015). Bergey’s Manual of Systematics of Archaea and Bacteria. https://doi.org/10.1002/9781118960608
6. COL | The Catalogue of Life, Accessed: 01.03.2024
7. Rüthi, J., Bölsterli, D., Pardi-Comensoli, L., Brunner, I., & Frey, B. (2020). The “Plastisphere” of Biodegradable Plastics Is Characterized by Specific Microbial Taxa of Alpine and Arctic Soils. In Frontiers in Environmental Science (Vol. 8). Frontiers Media SA. https://doi.org/10.3389/fenvs.2020.562263
8. Rüthi, J., Cerri, M., Brunner, I., Stierli, B., Sander, M., & Frey, B. (2023). Discovery of plastic-degrading microbial strains isolated from the alpine and Arctic terrestrial plastisphere. In Frontiers in Microbiology (Vol. 14). Frontiers Media SA. https://doi.org/10.3389/fmicb.2023.1178474
9. Lapanje, A., Wimmersberger, C., Furrer, G., Brunner, I., & Frey, B. (2011). Pattern of Elemental Release During the Granite Dissolution Can Be Changed by Aerobic Heterotrophic Bacterial Strains Isolated from Damma Glacier (Central Alps) Deglaciated Granite Sand. In Microbial Ecology (Vol. 63, Issue 4, pp. 865–882). Springer Science and Business Media LLC. https://doi.org/10.1007/s00248-011-9976-7
10. BRUNNER, I., PLÖTZE, M., RIEDER, S., ZUMSTEG, A., FURRER, G., & FREY, B. (2011). Pioneering fungi from the Damma glacier forefield in the Swiss Alps can promote granite weathering. In Geobiology (Vol. 9, Issue 3, pp. 266–279). Wiley. https://doi.org/10.1111/j.1472-4669.2011.00274.x
11. Frey, B., Rieder, S. R., Brunner, I., Plötze, M., Koetzsch, S., Lapanje, A., Brandl, H., & Furrer, G. (2010). Weathering-Associated Bacteria from the Damma Glacier Forefield: Physiological Capabilities and Impact on Granite Dissolution. In Applied and Environmental Microbiology (Vol. 76, Issue 14, pp. 4788–4796). American Society for Microbiology. https://doi.org/10.1128/aem.00657-10
12. Pontes, A., Ruethi, J., Frey, B., Aires, A., Thomas, A., Overy, D., Halti, B., Kerr, R., & Sampaio, J. P. (2020). Cryolevonia gen. nov. and Cryolevonia schafbergensis sp. nov., a cryophilic yeast from ancient permafrost and melted sea ice. In International Journal of Systematic and Evolutionary Microbiology (Vol. 70, Issue 4, pp. 2334–2338). Microbiology Society. https://doi.org/10.1099/ijsem.0.004040
13. Frasson, D., Udovičić, M., Frey, B., Lapanje, A., Zhang, D.-C., Margesin, R., & Sievers, M. (2015). Glaciimonas alpina sp. nov. isolated from alpine glaciers and reclassification of Glaciimonas immobilis Cr9-12 as the type strain of Glaciimonas alpina sp. nov. In International Journal of Systematic and Evolutionary Microbiology (Vol. 65, Issue Pt_6, pp. 1779–1785). Microbiology Sohttps://doi.org/10.1099/ijs.0.000174